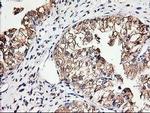
TUBB4 Antibody in Immunohistochemistry (Paraffin) (IHC (P))

Search
OriGene
TUBB4 Monoclonal Antibody (OTI5C1), TrueMAB™
{{$productOrderCtrl.translations['antibody.pdp.commerceCard.promotion.promotions']}}
{{$productOrderCtrl.translations['antibody.pdp.commerceCard.promotion.viewpromo']}}
{{$productOrderCtrl.translations['antibody.pdp.commerceCard.promotion.promocode']}}: {{promo.promoCode}} {{promo.promoTitle}} {{promo.promoDescription}}. {{$productOrderCtrl.translations['antibody.pdp.commerceCard.promotion.learnmore']}}
产品信息
CF503129
宿主/亚型
分类
类型
克隆号
抗原
偶联物
形式
浓度
规格
保存条件
运输条件
产品详细信息
For reconstitution, we recommend adding 100 µL distilled water to a final antibody concentration of about 1 mg/mL. To use this carrier-free antibody for conjugation experiments, we strongly recommend performing another round of desalting. (Zeba Spin Desalting Columns, 7KMWCO, 0.5 mL, Product # 89882)
靶标信息
TUBB4A (beta-4 tubulin) encodes a member of the beta tubulin family. Beta tubulins are one of two core protein families (alpha and beta tubulins) that heterodimerize and assemble to form microtubules. Mutations in this gene cause hypomyelinating leukodystrophy-6 and autosomal dominant torsion dystonia-4. Alternate splicing results in multiple transcript variants encoding different isoforms. A pseudogene of this gene is found on chromosome X.
仅用于科研。不用于诊断过程。未经明确授权不得转售。